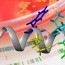
分子生物學(xué)試劑盒與酶制劑

關(guān)于金福賽
金福賽(Gene-Foci Biotech)總部位于美國(guó)密歇根州安娜堡。我們致力于為生命科學(xué)研究提供尖端技術(shù)、高品質(zhì)和極具價(jià)格競(jìng)爭(zhēng)力的高端科研試劑產(chǎn)品,為迅猛發(fā)展的基因組學(xué)、蛋白質(zhì)組學(xué)、臨床診斷等領(lǐng)域提高科研水平、應(yīng)用新技術(shù)而不懈努力!
我們依托強(qiáng)大的科研實(shí)力和技術(shù)創(chuàng)新,不斷研發(fā)有強(qiáng)大競(jìng)爭(zhēng)力的新產(chǎn)品。創(chuàng)新生命科技,共創(chuàng)美好未來(lái)!
科技
Be Innovative
客戶(hù)
Custmer First
價(jià)值
Bring Values










![發(fā)現(xiàn) [Gene-Foci Biotech]](http://dxelgso.cn/wp-content/uploads/dis2.png)

地點(diǎn): 北京中關(guān)村生物醫(yī)藥產(chǎn)業(yè)基地天榮街19號(hào)
電話(huà): 010-67260188
手機(jī): 18810892505
Email: info@gene-foci.com